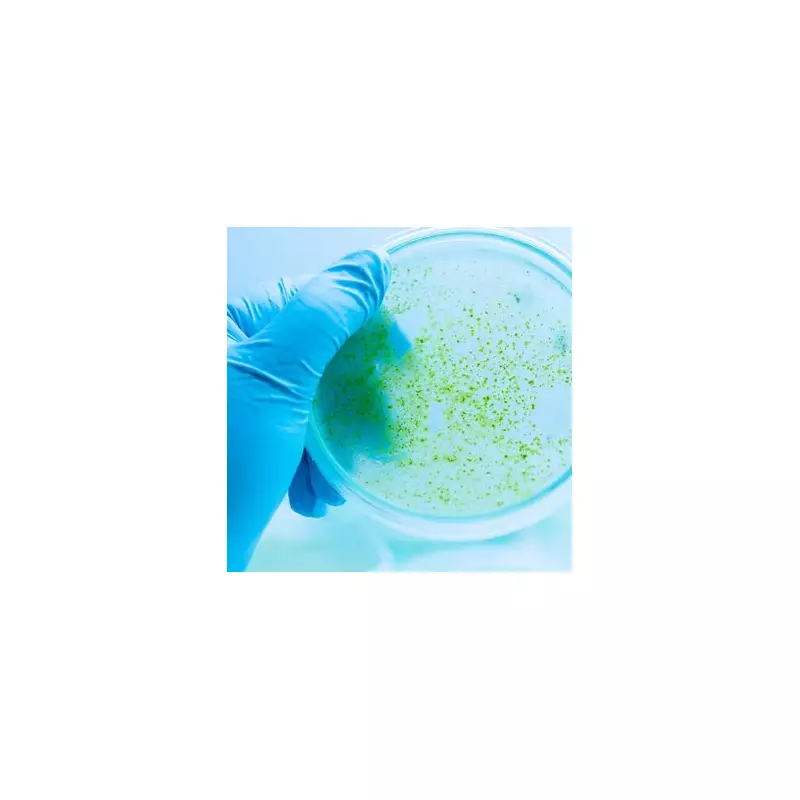
Deadly Danger in Your Home: Experts Warn About Common Toxic Substance

Health experts have sounded the alarm over a shockingly common household substance that's putting families at serious risk of poisoning across the UK.
The Hidden Hazard in Your Cupboard
New research reveals that an everyday product found in nearly every home could cause devastating health consequences if accidentally ingested. The substance, which many parents wouldn't think twice about storing in their kitchen or bathroom, has been responsible for a worrying number of poisoning cases recently.
Children Most at Risk
Medical professionals report that young children are particularly vulnerable to accidental poisoning from this toxic material. "We're seeing cases where toddlers have accessed these substances thinking they're food or drink," explained a senior toxicologist. "The effects can be life-threatening within minutes."
Warning Signs Every Parent Should Know
Symptoms of poisoning include:
- Severe vomiting and nausea
- Difficulty breathing
- Burns around the mouth
- Sudden drowsiness or confusion
If you suspect poisoning, call 999 immediately. Do not try to make the person vomit as this could cause further damage.
How to Protect Your Family
Safety experts recommend:
- Storing all toxic substances in locked cabinets
- Keeping products in their original containers
- Never transferring substances to food or drink containers
- Educating older children about the dangers
Public Health England is working with retailers to improve packaging and warning labels on these potentially deadly products.









